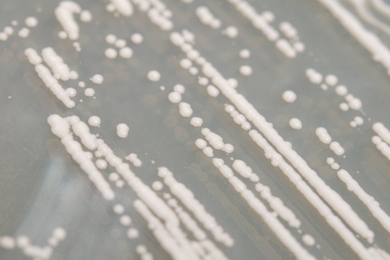

Seeing Green: Saving Forests or Food Prices?
A growing population and rapid development will put a strain on land used to grow food over the next century. But if reforestation is used to avoid climate change it will create further strain, says a new MIT study.